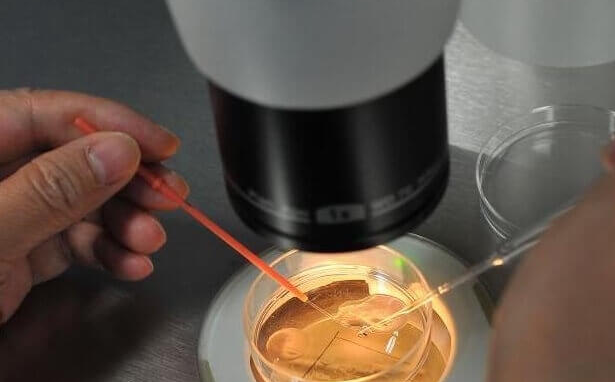

在辅助生殖技术领域,人工授精与试管婴儿是两种核心手段,但两者在技术原理、适用人群及成功率上存在显著差异。选择合适的治疗方案需基于个体化的医学评估,以下从三大维度展开深度解析。
一、技术原理:体内结合 vs 体外培养
人工授精通过非性交方式将优化处理后的精子直接注入女性子宫腔,模拟自然受孕过程,精卵在体内完成结合。该技术适用于输卵管功能正常、子宫内膜环境良好的人群,操作简便且接近自然生理状态。
试管婴儿技术则需经历完整的体外操作流程:通过促排卵药物获取多枚卵子,在实验室环境下完成精子卵子结合与胚胎培养,最终将优质胚胎移植回子宫。此过程涉及卵子采集、体外受精、胚胎筛选等精密操作,技术复杂度远高于人工授精。
二、适用人群:精准定位生育难题
1、人工授精的核心适应症
男性因素:针对少精症(精子浓度<1500万/ml)、弱精症(前向运动精子<32%)及畸形精子症,通过精子洗涤技术提升受精概率。
女性排卵障碍:多囊卵巢综合征患者经促排卵治疗后,配合人工授精可提高妊娠率。
性功能障碍:勃起障碍或早泄患者,通过医疗手段绕过性交障碍。
生殖道异常:阴道狭窄、宫颈黏液异常等阻碍精子通过的情况。
2、试管婴儿的强制指征
输卵管性不孕:双侧输卵管阻塞或严重积水导致精卵无法相遇。
重度男性不育:梗阻性无精症需经睾丸穿刺取精,或严重少弱畸精症需单精子注射技术(ICSI)。
子宫内膜异位症:中重度内异症患者自然妊娠率极低。
不明原因不孕:经3次人工授精失败后,需考虑试管婴儿。
遗传疾病防控:通过植入前遗传学诊断(PGD)阻断遗传病传递。
三、成功率:年龄与技术的双重博弈
1、人工授精的成功率特征
单周期成功率约10%-20%,35岁以下女性因卵巢功能较好,成功率可达15%-20%。累计3个周期治疗可使成功率提升至30%-40%。供精人工授精在受体条件优良时,单周期成功率接近25%。
2、试管婴儿的成功率梯度
整体成功率约40%-60%,但存在显著年龄分层:
30岁以下:50%-60%
30-35岁:45%-50%
38-40岁:30%-40%
40岁以上:20%-30%
实验室条件与操作技术对成功率影响显著。采用胚胎辅助孵化、时差成像培养箱等先进技术,配合经验丰富的胚胎师团队,可使成功率提升5%-10%。
对于年轻、输卵管通畅且男性轻度少弱精的患者,人工授精因其创伤小、费用低成为首选。若存在输卵管阻塞、重度男性不育或反复人工授精失败,则需转向试管婴儿技术。
值得注意的是,试管婴儿技术虽能解决更多生育难题,但伴随多胎妊娠、卵巢过度刺激综合征等风险。因此,临床决策需综合评估患者年龄、病因、经济条件及心理承受能力,制定最符合个体需求的生殖方案。






































